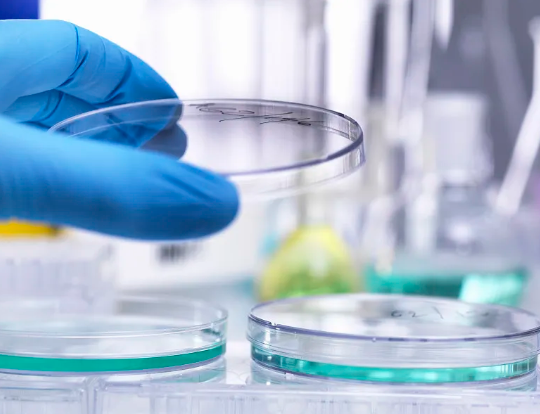
image.png

幹細胞采集存儲流程費用
2024-09-17 14:51:41 來源: 小編 咨詢醫生
幹細胞作爲一種具有廣泛應用前景的生物資源,其采集、存儲及應用越來越受到社會的關注。特别是在醫療、科研和美容等領域,幹細胞的用途不斷拓展。那麽,幹細胞的采集和存儲流程是什麽樣的?費用又如何?本文将對此進行深入探讨。
一、幹細胞的基本概念
幹細胞是指一種具有自我複制能力和分化潛能的細胞,能夠分化爲多種類型的細胞。根據來源的不同,幹細胞可以分爲胚胎幹細胞和成人幹細胞,後者則是從成年人或者新生兒的組織中提取。随着科學技術的發展,流行于健康管理和再生醫學的幹細胞療法逐漸開始普及。
二、幹細胞采集流程
1.咨詢與評估
在進行幹細胞采集前,患者需首先與專業醫療機構進行咨詢。醫生會根據患者的健康狀況、病史以及需求進行詳細評估。
2.采集準備
一旦确認進行幹細胞采集,患者需進行一系列的準備工作。包括基本的體檢、查血等,以确保身體健康,适宜進行采集。
3.幹細胞采集
臍帶血采集:對于新生兒,通常是在分娩後,從臍帶中采集臍帶血。采集過程簡便,無痛,且在寶寶出生後的1小時内完成。
脂肪組織采集:對于成年人,通常通過微創手術從腹部或大腿部位提取脂肪,并通過離心處理分離出幹細胞。
骨髓采集:通過針頭從骨髓中提取細胞,這通常在局部麻醉下進行。
4.幹細胞處理
采集後的幹細胞需經過嚴格的處理和培養,以确保其活性和質量。這一過程包括分離、清洗和培養等。
5.存儲
經處理合格的幹細胞被轉移至專業的冷凍儲存設備中,以196°C的極低溫進行長時間保存。這樣可以保證幹細胞的活性與可用性,在未來需要使用時仍然具備良好的生物活性。
三、幹細胞存儲費用
幹細胞的采集和存儲費用受多個因素的影響,包括:
1.采集方式的不同
臍帶血采集費用通常較低,約在幾千元至一萬多元之間。脂肪組織和骨髓的采集由于手術複雜性較高,費用通常在幾千到數萬元不等。
2.存儲年限
通常,幹細胞的存儲費用是按年計算的,第一年的存儲費用可達數千元,後續年度可能會有折扣優惠,但整體費用随着存儲年限增加而增加。
3.醫療機構的收費标準
不同的醫療機構在采集、處理及存儲費用上有所不同,建議患者在選擇服務時進行充分的比較和評估。
4.附加服務
一些幹細胞存儲機構可能提供附加服務,如健康咨詢和幹細胞應用指導,這也會影響總費用。
文章來源:https://www.2008eshop.cn/ganxibao/37708.html
-
下一頁: 胎盤幹細胞存儲服務,費用是多少
- 2024-11-07哪家幹細胞存儲機構口碑最佳?選擇技巧有哪些?
- 2024-10-09安康臍帶幹細胞存儲需要多少錢,費用差異原因何在
- 2024-07-30臍帶間充質幹細胞存儲費用,臍帶間充質幹細胞需要配型嗎
- 2024-08-10牙髓幹細胞存儲費用,牙髓幹細胞存儲作用大嗎
- 2024-09-09深圳儲存幹細胞費用,多少錢一年
- 2024-09-27造血幹細胞儲存流程複雜嗎?哪些機構提供儲存服務?
- 2024-10-07造血幹細胞在人體中如何分布?對健康有哪些影響?
- 2024-07-30幹細胞修複療法,幹細胞修複的原理是什麽
- 2024-09-05貝拉國際醫療中心是正規醫院嗎,貝拉國際醫療中心簡介
- 2024-09-05幹細胞的自體療法怎麽做,要做多久
- 2024-10-09烏克蘭幹細胞針是否有明顯效果?與國内相比如何?
- 2024-09-04幹細胞療法可以治療哪些病,多少錢一針
- 2024-07-22幹細胞移植費用,幹細胞移植成功率高嗎
- 2024-10-03臍帶血幹細胞移植費用,哪些因素影響其價格
- 2024-09-09卵巢早衰幹細胞治療費用大概多少
- 2024-09-06幹細胞多久有效果呢,打完幹細胞多久能看到效果
- 2024-09-18幹細胞注射後美容效果附注意事項
- 2024-09-05幹細胞移植治療腦梗塞效果好嗎,幹細胞可以治療腦梗嗎
